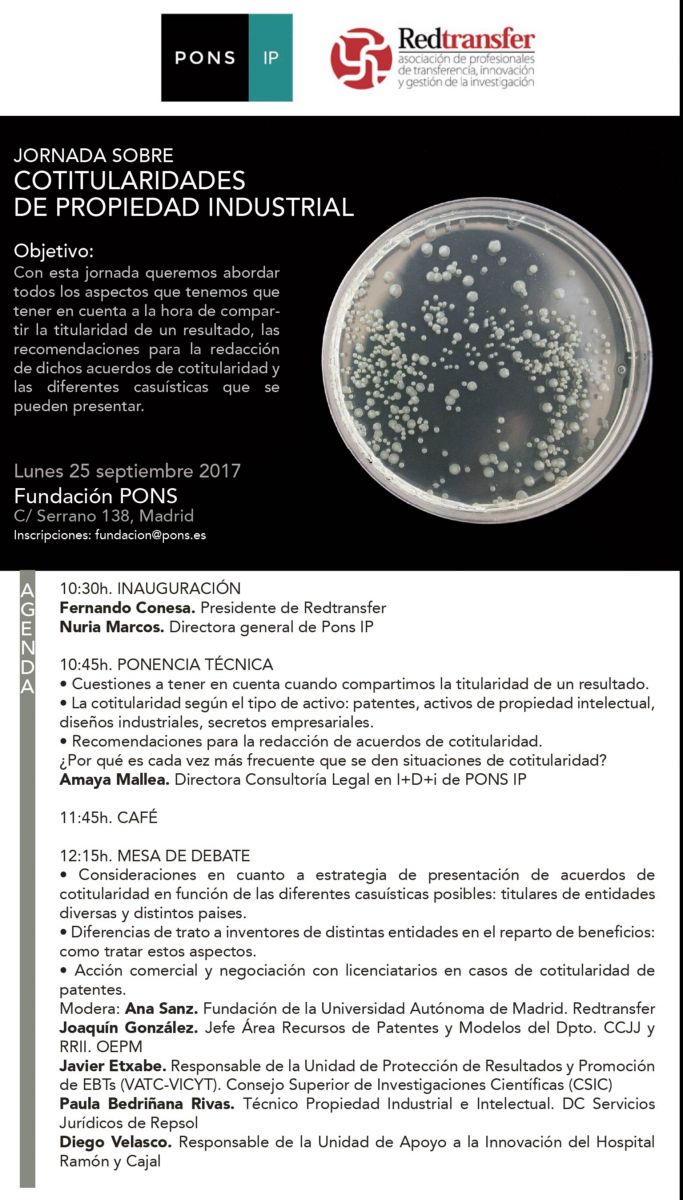

Jornada sobre cotitularidades de propiedad industrial
Jornada - Propiedad Industrial (presencial)
Agenda Cotitularidad Derecho Fundación Pons Normativa Pons Propiedad Industrial
Madrid
(Madrid)
Leer más
-------------------
Obra recomendada por Lefevbre - El Derecho para esta materia: Memento Ejercicio Profesional de la Abogacía 2016-2017
Organizadores
Fundación PONS
Añadir a calendario
